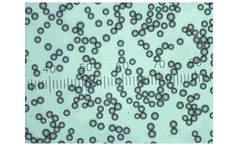
Applied-Physics - Polystyrene Microsphere Dry Powder

- Home
- Equipment
- canada ontario
- pharmaceutical sight glass application
Refine by
Applications
- Monitors, gas analyzers solutions for ISO 14644-1/2: 2015 insights & solutions
- Industrial Filters for Steel Plant
- Industrial Filters for Power Generation
- Plate Bending Machines for Ship Building
- Plate Bending Machines for Rocket Shells
- Plate Bending Machines for Metal Fabrication
- Dry bulk material processing for the food industry
- Dry bulk material processing for the mining & minerals industry
- Dry bulk material processing for the plastic industry
- Shredding solutions for PET bottles recycling
- Shredding solutions for computer hard disks
- Shredding solutions for hospital waste industry
- Shredding solutions for aluminum cans
- Shredding solutions for textile and carpets industry
- Monitors, gas analyzers solutions for pharmaceuticals / life sciences sector
- Monitors, gas analyzers solutions for semiconductor / microelectronics sector
- Monitors, gas analyzers solutions for aerospace & defense industry
- Progressive Cavity Pumps for Chemical Industry
- Progressive Cavity Pumps for Ceramic Industry
- Progressive Cavity Pumps for Oil & Gas Industry
- Progressive Cavity Pumps for Fertilizers Industry
- Progressive Cavity Pumps for Marine Feed Industry
- Shredding solutions for automotive components
- Shredding solutions for scraps and purge production waste
- Shredding solutions for Electronic Waste (WEEE)
- Shredding solutions for Aluminum SWARFS
- Shredding solutions for Metal SWARFS
- Determination of dyes in beverages
- Quality control of milk and milk products
- Determination of amino acids
- Analytical instruments for pharma & life science industry
- Legionella Bacteria for Treatment
- Bio-Hydrox for Treatment Plants
- Bio-Hydrox for Oil, Gas & Energy
- Bio-Hydrox for Water Wells
- Bio-Hydrox for Aquaculture
- Bio-Hydrox for Recreational
- Laboratory Fume Hood Exhaust for Hospitals
- Laboratory Fume Hood Exhaust for Laboratories
- Laboratory Fume Hood Exhaust for Government Facilities
- Rain Rfid Cattle Ear Tag for Animal ID
- Process and Separation Technological Solutions for Chemical
- Process and Separation Technological Solutions for Pharmaceutical
- Diaphragm Metering and Process Pumps for Gas Distribution Network
- QUA - Industrial Water Filtration
- Water Recycling / Water Reuse
- Steam Injection for Food and Beverage Processing
- Heat Exchangers Solutions for Evaporation & Concentration of Environmental Waste Streams Sector
- Heat Exchangers Solutions for Pasteurisation of Sludge Sector
- Heat Exchangers Solutions for Sewage Treatment Industry
- Heat Exchangers Solutions for for Waste Water Industry
- Heat Exchangers Solutions for Anaerobic Digestion (AD) and Biogas Industry
- Heat Exchangers Solutions for Biodiesel Industry
- Heat Exchangers Solutions for Bioethanol Industry
- Heat Exchangers Solutions for Vegetable Oils Industry
- Heat Exchangers Solutions for Lotions, Creams & Gels Sector
- Heat Exchangers Solutions for Palm Oil Sector
- Heat Exchangers Solutions for Fine Chemicals Sector
- Heat Exchangers Solutions for Solvent Sector
- Heat Exchangers Solutions for Petrochemicals Industry
- Heat Exchangers Solutions for Process Water Industry
- Peristaltic pump solutions for custom applications industry
- Activated Carbon for Chemical & Bulk Drug Industries
- Activated Carbon for Food & Beverage Industries
- Activated Carbon for Water Purification Industries
- Activated Carbon for Effluent Treatment Plants
- Water Pollution Control and Recovery Equipment for Oil & Grease Removal
- Water Pollution Control and Recovery Equipment for Oily Water Treatment
- Water Pollution Control and Recovery Equipment for Coolant Recovery Systems
- Activated Carbon for Air & Gas Treatment
- Activated Carbon for Automotive
- Chemicals Products for Agriculture and Breeding
- Gas-Scrubbing Plant for Odour Control
- Shell and Tube Heat Exchanger and Pressure Vessel for Nuclear Power
- Pressure Vessels, Reactors, Columns, Heat Exchangers for DOE
Pharmaceutical Sight Glass Application Equipment & Supplies In Canada Ontario
908 equipment items found
Premium
Manufactured by:Analytik Jena - an EndressHauser Company based inJena, GERMANY
The creators behind the UVP GelStudio imaging systems are renowned for delivering advanced solutions to genomic and proteomic applications. UVP GelStudio imagers offer high-resolution and sensitive imaging of DNA & protein gels. They also work with an unlimited range of excitable stains and dyes. All imagers run the powerful VisionWorks® Software, full package image capture, enhancement ...
Premium
Manufactured by:BD|SENSORS GmbH based inThierstein, GERMANY
The pressure transmitter DCT 553P is used in the food and pharmaceutical industries or in applications where a dead space-free process connection is required. A capacitive ceramic pressure sensor developed in-house is used as the basic sensor, which is characterized by a high overload and excellent surface quality. The special design prevents the formation of condensation inside the pressure ...
Premium
Manufactured by:Applied Physics based inTampa, FLORIDA (USA)
Applied Physics USA Provides Polystyrene Dry Powder, Particle Size Standards. PSL Spheres, polystyrene latex beads, calibrated polymer micro-spheres for particle size standards used to calibrate airborne optical particle counters. OPC counters are required to meet ISO 21501-4 requirements for size ...
Premium
Manufactured by:Analytik Jena - an EndressHauser Company based inJena, GERMANY
Free yourself from repetetive manual pipetting. Save valuable laboratory space. Expand your experimental possibilities. Be ready for upcoming ...
Premium
Manufactured by:Analytik Jena - an EndressHauser Company based inJena, GERMANY
The UVP GelSolo is a compact, easy-to-use, stand-alone system for gel documentation. It is designed to acquire gel images easily and without any need for training. Thus, it is ideal for multi-user laboratories and practical trainings. The UVP GelSolo system includes a light-sensitive monochrome camera with a high resolution of 5 megapixels. A highly sensitive zoom lens allows for high-contrast ...
Premium
Manufactured by:Randolph Austin Company based inManchaca, TEXAS (USA)
The TP 1000 V is designed as an exact dose, extremely precise metering or bottling peristaltic pump. The TP 1000 V can be operated in a semiautomatic mode or be fully integrated through the RS232 as an automatic filling or metering machine. With a flow rate range of .38 ml to .177 ml per minute, depending on tubing and rotor assembly selection, the TP 1000 V is an excellent choice for ...
Premium
Manufactured by:Hengst Air Filtration Denmark A/S based inNakskov, DENMARK
Suitable for dedusting systems with oval cartridges. Oval Cartridge Filters are high-quality dust extraction filters designed to suit all dry dust extraction systems that use oval filter cartridges. Engineered for superior filtration, their unique oval shape enhances airflow capacity, boosts system performance, and reduces energy consumption, making them an ideal solution for a variety of ...
Premium
Manufactured by:Hengst Air Filtration Denmark A/S based inNakskov, DENMARK
Pulse Jet 3 & 4 Lug cartridges, also known as Twist & Fix cartridges, are designed for a wide range of filtration applications to help prevent harmful dust emissions. They attach securely to the system using three or four lugs and can be installed from either the clean or raw gas side, ensuring a completely tight seal with the dust removal ...
Premium
Manufactured by:Vobis LLC based inEaston, PENNSYLVANIA (USA)
Spheronizers (also known as spheroidizers) are implemented to create spherical products that are more attractive or to fulfill specific product performance characteristics. Our Spheronizers produce uniform spheres for a wide range of technical as well as marketing driven reasons. ...
Premium
Manufactured by:Applied Physics based inTampa, FLORIDA (USA)
The Model 6162 is a unique anemometer designed for specialized high-temperature testing. Some of the primary applications of a mid-high temperature anemometer include: drying process control, forming process control, exhaust air measurement, and device performance testing (such as industrial ...
Premium
Manufactured by:Vobis LLC based inEaston, PENNSYLVANIA (USA)
Our Basket Extruders provide the lowest pressure method of wet extrusion combined with moderate sheer. To form granules from 0.5 to 4.5 mm in diameter, our basket extruders provide a very versatile means of wet extrusion. They produce consistent extrudates from wetted powders at laboratory through multiple ton per hour production extrusion rate capacities. ...
Premium
Manufactured by:SnowPure Water Technologies based inSan Clemente, CALIFORNIA (USA)
SnowPure has been providing EDI technology to the pharmaceutical and medical markets since 1987. We have installations in over 75 countries including the United States, India, Europe, Japan, China, and Southeast Asia. Our EDI products are integral components in validated installations that require complying with the harmonized USP (US Pharmacopoeia), JP (Japanese Pharmacopoeia), and EP (European ...
Premium
Manufactured by:Metrohm AG based inHerisau, SWITZERLAND
The Process Ion Chromatograph from Metrohm Process Analytics offers unattended, high precision analyses for a wide spectrum of ionic species in aqueous media. The Process IC is available with either one or two measurement channels, along with integrated liquid handling modules and several automated sample preparation options. System modularity, combined with Metrohm’s decades of experience ...
Premium
Manufactured by:Teledyne Gas and Flame Detection based inArras Cedex, FRANCE
The BM25 packs the benefits of a fixed system area monitor into a rugged, user-friendly and transportable instrument. It was designed to detect one to five gases for mobile or temporary work applications, team protection, area surveillance or places where fixed detection systems are not suitable. Powered by a NiMH battery pack, the BM 25 multi gas monitor offers up to 170 hours of continuous run ...
Premium
Manufactured by:Lumex Instruments based inMission, BRITISH COLUMBIA (CANADA)
Capel-105M is a high performance capillary electrophoresis system for fast and effective solutions in food industry, environmental applications, pharmaceutical and chemical industries, biochemistry and forensic ...
Manufactured by:MIRAI INTEX s.r.o. based inBrno, CZECH REPUBLIC
Introducing the MIRAI X CRYO, our latest innovation in cryochiller technology. This advanced refrigeration system is tailored to meet the diverse needs of industries ranging from semiconductor manufacturing to vacuum drying and pharma ...
Manufactured by:GEA based inHudson, WISCONSIN (USA)
Open channel design allows it to be used for products with very high viscosity, particularly suited for high solids pharmaceutical and food ...
Manufactured by:Bausch+Ströbel based inIlshofen, GERMANY
The CombiSys LBC 40606 machine by Bausch+Ströbel is engineered to cater to advanced pharmaceutical processing needs, ensuring optimal efficiency and precision. This machine boasts a user-friendly centralized operation system, allowing for streamlined control with minimal setup time. Its compact design maximizes workspace efficiency, while the optimized laminar air flow guarantees consistent ...
Manufactured by:Doshion Polyscience Pvt. Ltd. based inAhmedabad, INDIA
Principal Application: Taste masking of bitter drugs in suspension/ tablets/ dry ...
Manufactured by:Doshion Polyscience Pvt. Ltd. based inAhmedabad, INDIA
Principal Application: Taste masking of bitter drugs in suspension/ ...